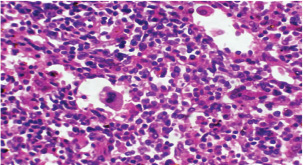

| Research Article | ||
Open Vet. J.. 2025; 15(8): 3719-3726 Open Veterinary Journal, (2025), Vol. 15(8): 3719-3726 Research Article Experimental induction of Theileria annulata infection in rabbits: Immunopathological, biochemical, and histopathological analysisMohanad Abbas Talab* and Inam Badr FalihDepartment of Pathology and Poultry Diseases, College of Veterinary Medicine, University of Baghdad, Baghdad, Iraq *Corresponding Author: Mohanad Abbas Talab. Department of Pathology and Poultry Diseases, College of Veterinary Medicine, University of Baghdad, Baghdad, Iraq. Email: Mohannad.Abbas2207p [at] covm.uobaghdad.edu.iq Submitted: 14/03/2025 Revised: 29/06/2025 Accepted: 09/07/2025 Published: 31/08/2025 © 2025 Open Veterinary Journal
ABSTRACTBackground: Theileria annulata is a protozoan parasite transmitted by ticks that primarily affects cattle and causes tropical theileriosis. This disease is widespread in tropical and subtropical regions and leads to significant economic losses due to fever, anemia, weight loss, and high mortality, especially in susceptible breeds. Infecting rabbits with T. annulata was done to study their immunological and pathological responses in rabbits experimentally infected with T. annulata. Methods: The study included 24 male rabbits divided into two groups (12 rabbits per group). The first group was injected with sterile distilled water and considered the control group. The second group was injected intraperitoneally with a single dose of 0.5 ml of blood from infected cattle containing approximately 3 × 106 T. annulata-infected erythrocytes. Rabbits were selected as an experimental model due to their practicality, distinct immune responses, and suitability for controlled studies of T. annulata pathogenesis. After 14 and 21 days of infection, samples were collected from the rabbits for histopathological and immunological analysis. Results: Theileria annulata piroplasms were observed under a microscope as commas, spots, and rods. The progression of infection was associated with increased body temperature, which is closely related to theileriosis. The infection caused a considerable temperature increase of 39.7°C on the seventh day and 41°C on the thirteenth day. In the infected group, Interferon-gamma (IFN-γ) levels were significantly elevated, whereas IL-10 levels were markedly reduced. Transforming growth factor-beta 1 (TGF-β1) levels displayed a dynamic temporal pattern. The markers of oxidative stress showed a significant increase in malondialdehyde (MDA) levels and a notable decrease in total antioxidant capacity (TAC) levels. Furthermore, infection induces a substantial rise in Immunoglobulin G (IgG) concentrations. Rabbits infected with T. annulata had severe histological abnormalities in their lungs, liver, spleen, kidneys, and mesenteric lymph nodes. Conclusion: The infection altered the red blood cell structure of the host, as well as increased body temperature and mortality. Increased levels of proinflammatory markers (e.g., IFN-γ), decreased levels of antiinflammatory cytokines (IL-10 and TGF-β1), higher oxidative stress (e.g., MDA, reduced TAC), and persistent IgG responses indicate systemic immunological activation. Histopathological changes revealed increased lung, liver, spleen, kidney, and lymph node damage. Keywords: Tropical theileriosis, Experimental infection, Histopathological changes, Immunological analysis. IntroductionTheileriosis is one of the most widespread tick-borne diseases, posing a serious threat to 250 million animals at risk of infection (Ullah et al., 2022). It is responsible for high morbidity and mortality rates, leading to significant reductions in milk and meat production (Kawan, 2019). Theileria spp. are obligate intracellular parasites that infect domestic animals and cause severe losses in tropical and subtropical regions (Clift et al., 2021). Theileria parasites have a complex life cycle involving two hosts that pass through morphologically distinct stages: the bovine (mammalian) host and the tick (vector host). This alternation between the bovine and tick hosts is essential for continuing the parasite’s life cycle and its spread (Shaw, 2003). The parasite reproduces sexually in lymphocytes, macrophages, monocytes, and erythrocytes of the mammalian host and asexually in ticks that carry the parasite (Clift et al., 2020). Theileria annulata causes tropical theileriosis, which is transmitted by ticks of the genus Hyalomma (Ma et al., 2020). Thin blood and lymph node smears, along with the clinical signs shown by the infected animal, are usually enough to confirm that the infection is T. annulata (Tuli et al., 2015). Detecting parasitic infection may be difficult if the incidence of T. annulata is very low, especially in subclinical or chronic cases (ALani and Yousif, 2023). One of the most important reasons for the severity of the epidemic of T. annulata is the occurrence of subclinical infection in endemic areas. Cattle are chronic carriers with the possibility of transmission of the infection to ticks, thereby further spreading the disease (Saravanan et al., 2011). Investigating the immunopathological and histopathological effects of T. annulata in rabbits provides valuable insights into host–parasite interactions, disease mechanisms, and immune responses. Materials and MethodsExperimental designFrom January to May 2024, 24 healthy juvenile rabbits (O. cuniculus) aged 8–9 weeks were used in this study. The rabbits were housed in the animal house of the College of Veterinary Medicine, University of Baghdad, under controlled conditions (temperature: 20°C ± 5°C; relative humidity: 50% ± 5%; 14/10-hour light/dark cycle), with continuous access to water and pellets throughout the experiment. The bedding was regularly replaced to maintain a hygienic environment. Rabbits were divided equally into two groups (n=12). The first group (G1) received an intraperitoneal injection of sterile distilled water as the control. The second group (G2) was injected intraperitoneally with a single dose of 0.5 ml of blood from infected cattle containing approximately 3 × 106 T. annulata-infected red blood cells (Hashimoto et al., 2020; Ramzan et al., 2022). Two types of blood samples were collected from each rabbit, the first containing anticoagulant and the second without anticoagulant. The first samples (0.5 ml) were used for microscopic examination. After collection, all Ethylenediaminetetraacetic acid-containing tubes were gently inverted five times to ensure proper mixing. To collect serum, the second samples (2 ml) were separated by centrifugation at 3,000 rpm for 15 minutes and maintained at −80°C until use for enzyme-linked immunosorbent assay (ELISA) (Razmi et al., 2019; Özdek et al., 2020). Microscopic analysisThin blood films were stained with Giemsa stain at a concentration of 5% for 30–60 minutes and were viewed under a light microscope. Thin blood smears were used to determine the shape and measurement requirements for laboratory evaluation to diagnose the Theileria parasite (Al-Rhman et al., 2009; Alsaadi and Faraj, 2020). Parasitemia levels were quantified using the method described by Hashimoto et al. (2020). Immunological analysisFor immunological analysis, blood samples were collected on days 14 and 21 postinfection. After serum separation, the concentrations of Interferon-gamma (IFN-γ, pg/ml), Interleukin-10 (IL-10, pg/ml), and transforming growth factor-beta 1 (TGF-β1, ng/ml) were measured using commercial sandwich ELISA kits, while Immunoglobulin G (IgG, µg/ml) levels were assessed using an indirect ELISA kit (Elabscience, USA), following the manufacturer’s instructions. Briefly, for cytokines (IFN-γ, IL-10, and TGF-β1), 100 µl of diluted standard, blank, or serum sample was added to designated wells of a 96-well microplate and incubated at 37°C for 90 minutes. All measurements were performed in duplicate. After decanting the wells (without washing), 100 µl of a biotinylated detection antibody working solution was added. The plates were sealed and incubated for 1 hour at 37°C. The wells were then washed three times using 350 µl of wash buffer per well (with 1-minute soaking), followed by gentle drying on absorbent paper. Then, 100 µl of horseradish peroxidase (HRP)-conjugated working solution was added to each well, and the mixture was incubated for 30 minutes at 37°C. After five additional wash cycles, 90 µl of substrate reagent was added, and the plates were incubated in the dark at 37°C for approximately 15 minutes. The reaction was stopped by adding 50 µl of a stop solution, and optical density (OD) was measured immediately at 450 nm using a microplate reader. For IgG detection, five wells were used for standard dilutions, one for blank samples, and the remaining for serum samples. Each well received 50 µl of standard, blank, or sample, followed by 50 µl of detection reagent A. The plate was gently shaken, sealed, and incubated at 37°C for 1 hour. After aspiration, the wells were washed five times with 350 µl of wash buffer, allowing a 1–2 minutes soak per cycle. Then, 90 µl of substrate solution was added, and the plate was incubated in the dark at 37°C for 10–20 minutes. The reaction was stopped with 50 µl of a stop solution, and the OD was measured at 450 nm. Biochemical serum analysisThe evaluation of oxidative stress biomarkers, including malondialdehyde (MDA, ng/ml) and total antioxidant capacity (TAC, U/ml), was conducted according to the manufacturer’s instructions (Elabscience, USA); MDA was quantified via a competitive ELISA kit, while TAC was assessed using a colorimetric assay. Blood samples were collected on days 14 and 21 post-infection, and serum samples were separated for analysis. For MDA determination, 50 µl of diluted standard, blank, or sample was added to each well, followed immediately by 50 µl of biotinylated detection antibody solution. The plates were sealed and incubated at 37°C for 45 minutes. After incubation, the wells were washed three times with 350 µl of wash buffer for each well and then incubated with 100 µl of HRP-conjugated working solution for 30 minutes at 37°C, followed by five additional washes. Subsequently, 90 µl of substrate reagent was added, and the mixture was incubated in the dark at 37°C for 15 minutes. The reaction was stopped by adding 50 µl of a stop solution. OD was measured at 450 nm. TAC levels were measured using a colorimetric method. In both the sample and control tubes (5-ml Eppendorf tubes), 1 ml of buffer solution was added. To the sample tube, 0.1 ml of serum was added, whereas the control remained without serum. Then, 2.0 ml of chromogenic working solution and 0.5 ml of ferric salt working solution were added to both tubes. After thorough mixing, the tubes were incubated at 37°C for 30 minutes. Subsequently, 0.1 ml of a stop solution was added to each tube. Then, 0.1 ml of serum was added to the control tube. The mixtures were allowed to stand for 10 minutes at room temperature. Absorbance was measured at 520 nm using a 1-cm quartz cuvette, with double-distilled water used for zeroing the spectrophotometer. Histopathological examinationHistological investigation of the experimental rabbits was conducted 21 days after the first day of the trial. Specimens were collected from the liver, spleen, mesenteric lymph node, and lung. The tissues were kept in a 10% formaldehyde solution and later processed according to normal technique. Paraffin blocks with cultured tissue slices were sectioned, stained with hematoxylin and eosin, and examined using light microscopy (Hassan et al., 2012). Statistical analysisThe Statistical Packages for the Social Sciences-SPSS (2019) program, version 25.0, was used for data analysis. The least significant difference (LSD) was used to significantly compare the means (ANOVA/Two and One way) in this study (SPSS, 2019). Ethical approvalApproval for this study was obtained from the committee of the College of Veterinary Medicine/University of Baghdad, Iraq. Number 118/PG on 20/1/2025. ResultsTheileri annulata appeared in various shapes, such as commas, dots, or rods, in addition to the deformation of red blood cells resulting from the effects of piroplasms or other shapes (Fig. 1). A significant increase in temperature was recorded at 39.7°C on the seventh day and a large increase to 41°C on the thirteenth day after the infection. Three rabbits in the infected group died, one on the 11th day and two on the 15th day postinfection (Figs. 2 and 3). This study revealed distinct immune and oxidative stress responses in the negative control and infected groups. We observed significant differences across all measured parameters (p ≤ 0.05) between the infection and control groups, highlighting the impact of infection on immune markers and oxidative stress indicators. In the IFN-γ response, the infected group exhibited a markedly higher IFN-γ response compared to the negative control. This suggests an upregulated proinflammatory immune response, which remained consistent across both time points (Table 1). IL-10 levels were significantly lower in the infected group than in the control group. This trend was more pronounced at the later stages of infection, indicating a decline in antiinflammatory regulation over time (Table 2). In the TGF-β1 response, the negative control group had stable levels of TGF-β1, while the infected group exhibited a trend that changed over time. Notably, the infected group’s response at the later stage became comparable to that of the control, suggesting a potential recovery or regulatory adaptation (Table 3). The infected group had significantly elevated MDA levels, indicative of lipid peroxidation, confirming increased oxidative stress due to infection. On the other hand, TAC levels, which indicate total antioxidant capacity, were much lower in the infected group, which added to the oxidative imbalance (Tables 4 and 5). In terms of IgG levels, infection led to a substantial increase, reflecting an activated humoral immune response. This increase persisted over time, indicating sustained immune activation (Table 6). These findings suggest that infection induces a strong proinflammatory and oxidative stress response while reducing antiinflammatory and antioxidant defenses. The increased IgG level highlights an active immune defense mechanism. The dynamic changes in these markers over time reflect the body’s attempts to regulate immune responses and counteract infection-induced stress.
Fig. 1. T. annulata inside erythrocytes (black arrow) in thin blood smears of infected rabbit stained by Giemsa stain (100×).
Fig. 2. Relationship between time (days) and temperature (°C) during T. annulata infection.
Fig. 3. Relationship between time (days) and Parasitemia (%) in T. annulata. Table 1. Effect of rabbit groups and period in the result of IFN-γ (pg/ml).
Table 2. Effect of rabbit groups and period in the result of IL-10 (pg/ml).
Table 3. Effect of rabbit groups and period in the result of TGF-β1 (ng/ml).
Histopathological examination of rabbits infected with T. annulata (G2) demonstrated progressive pathological alterations in various organs, in contrast to the control group (G1), which exhibited no abnormalities. At 14 days of post-infection, the lungs exhibited moderate alveolar thickening, hyperemia, and the presence of developed schizonts, indicating early tissue involvement (Fig. 4). The liver showed multiple necrotic areas, extensive venous congestion, and parasitized red blood cells, suggesting severe hepatic distress (Fig. 5). The spleen exhibited scattered macrophages containing microschizonts and hemosiderin-laden macrophages, reflecting both immune activation and erythrocyte breakdown (Fig. 6). The kidneys were affected by tubular infiltration with parasitized mononuclear cells (MNCs) (Fig. 7), whereas the mesenteric lymph nodes showed marked architectural disruption and merozoite aggregation (Fig. 8), suggesting significant immune system involvement. Table 4. Effect of rabbit groups and period in the result of MDA (ng/ml).
Table 5. Effect of rabbit groups and period in the result of TAC (U/ml).
Table 6. Effect of rabbit groups and period in the result of IgG (µg/ml).
At 21 days post-infection, the lungs display moderate venous dilation and congestion, with abnormal leukocytes, indicating ongoing vascular compromise (Fig. 9). The liver showed necrotic changes in the fibrous capsule region, focal inflammatory cell infiltration, and intact hepatic cords, indicating sustained but localized damage (Fig. 10). The spleen exhibited plasma cell and macrophage proliferation within the red pulp, mild sinus dilation, and a few megakaryocytes, suggesting chronic immune activation (Fig. 11). The kidneys showed atrophic glomerular tufts and cystic dilation of adjacent tubules, indicating worsening renal pathology (Fig. 12). The mesenteric lymph nodes showed lymphoid follicles containing abnormal plasma cells and macrophages within the necrotic foci (Fig. 13).
Fig. 4. A histopathological section of lung of (G2) at 14 days postinfection showing moderate thickening of alveolar tissue with presence number of developed schizonts accompanied by alveolar hyperemia (H&E stain X 40).
Fig. 5. A histopathological section of the liver of (G2) at 14 days postinfection exhibits multiple necrotic findings in the liver parenchyma with extensive venous congestion and dilatation associated with numbers of parasitized red blood cells (black arrow) (H&E stain X 40).
Fig. 6. A histopathological section of the spleen of (G2) at 14 days postinfection shows the scattered presence of macrophages containing micro-schizont (black arrow) and hemosiderin laden macrophages (red arrow) (H&E stain X 40).
Fig. 7. A histopathological section of kidney of (G2) at 14 days postinfection showing tubular infiltration with parasitized mononuclear cells (black arrow) (H&E stain X 40).
Fig. 8. A histopathological section of mesenteric lymph node of (G2) at 14 days postinfection showing marked disruption of the lymph node architecture (red arrow) with evidence of merozoites aggregation (black arrow) (H&E stain X 40).
Fig. 9. A histopathological section of lung of (G2) at 21 days postinfection showing moderate venus dilation and congestion with number of abnormal leukocytes (black arrow) (H&E stain X 40).
Fig. 10. A histopathological section of liver of (G2) at 21 days postinfection showing necrotic finding in fibrous capsule region (black arrow) with focal inflammatory cell filtration with intact hepatic cords (H&E stain X 40).
Fig. 11. A histopathological section of the spleen (G2) at 21 days postinfection showing the main splenic findings characterized by proliferation of the plasma cell and macrophages within red pulp tissue with mild sinus dilation and few megakaryocytes (H&E stain X 40).
Fig. 12. A histopathological section of the kidney (G2) at 21 days postinfection showing evidence of an atrophic tuft of many glomeruli recorded with cystic dilation of adjacent tubules (H&E stain X10).
Fig. 13. A histopathological section of the mesenteric lymph node of (G2) at 21 days postinfection showing a lymphoid follicle containing numbers of abnormal plasma cells and macrophages within necrotic foci (H&E stain X 40). DiscussionThe various forms of T. annulata were described by Abd Elsayed et al. (2024). There is a close relationship between theileriosis and the change in rabbits’ temperature. The stage of parasite development plays a major role in this change, and this is consistent with (Ramzan et al., 2022), who noted a significant positive correlation between rising body temperature and increasing parasitemia levels, with both parameters peaking simultaneously at day 14 post-infection. This temporal association suggests that the febrile response represents a host immune reaction to active parasite proliferation in peripheral blood. Researchers have demonstrated a strong correlation between the incremental rise in parasite prevalence in the blood and the corresponding increases in body temperature and mortality rates in calves (Sandhu et al., 1998). Our findings agree with (Onzere et al., 2024) in demonstrating that the highest rate of parasitemia in T. equi occurred at 14 days postinfection in horses. Our findings agree with Razmi et al. (2019) regarding the important role of pro-inflammatory cytokines, particularly IFN-γ, in the immunological response to T. annulata, with increased levels possibly associated with symptoms including fever and anemia. Similarly, Tümer and Kızıl (2023) reported a significant serum levels of IFN-γ were elevated in T. annulata-infected cattle compared with healthy cattle. The reduced IL-10 levels in T. annulata-infected rabbits than in uninfected controls may be attributed to the altered immune dynamics induced by the infection. As noted by Sudan and Paliwal (2024), proinflammatory cytokines can directly suppress IL-10 production by affecting its main sources, such as monocytes, dendritic cells, macrophages, and regulatory T cells. This imbalance may also reflect a parasite-driven strategy to evade host immune regulation. Plasmodium, like Theileria, is an apicomplexan protozoan parasite. Abosalif et al. (2023) highlighted that Plasmodium falciparum can downregulate IL-10 production in dendritic cells and macrophages while promoting the release of proinflammatory cytokines such as TNF-α and IFN-γ. The suppression of IL-10 may represent a parasite-driven strategy to evade host immune regulation. The reduction in serum TGF-β1 levels noted at the 14th and 21st days postinfection with T. annulata may be related to a more extensive cytokine network, resulting in alterations in the synthesis of many cytokines, including TGF-β1. For instance, elevated concentrations of proinflammatory cytokines such as IFN-γ or TNF-α may inhibit TGF-β1 production, while the parasite’s immune evasion mechanisms or the host’s attempts to manage the infection could result in diminished TGF-β1 levels. Our results agree with Abdel-Hamied et al. (2020), who noted a marked rise in MDA levels, coupled with an associated reduction in TAC, in the serum of animals afflicted by theileriosis; Also Al-Hosary et al. (2015) revealed that the MDA concentrations were significantly higher and TAC was significantly lower in infected cattle than in healthy ones. Oxidative stress was significantly altered, with a significant increase in TAC and an increase in MDA. Ryskeldina et al. (2024) demonstrated that T. annulata infection induces a humoral immune response characterized by the synthesis of IgG antibodies. Our findings agree with those reported by Abd-Elmaleck et al. (2015); the liver showed dilated sinusoids filled with macrophages and parasitized erythrocytes, and in the kidneys, infected erythrocytes were observed. The lungs of infected rats exhibited hyperemia and the presence of Theileria parasites. In addition, general structural alterations in the lungs were observed in the liver and kidneys. Babesia, like Theileria, is an intraerythrocytic protozoan parasite belonging to the phylum Apicomplexa (Sabbar and Aaiz, 2016), and our results are in agreement with those of Esmaeilnejad et al. (2018), who reported considerable histological alterations in Babesia bigemina-infected rats, including congested livers, hepatocyte cytoplasmic clearance, severe hydropic alterations, and dilated sinusoids with macrophages and parasitized erythrocytes, under the microscope. Extreme lymphoplasma cell infiltration was also present in the liver parenchyma. Liver macrophages were swollen and sometimes contained Babesia-parasitized erythrocytes. ConclusionThis study demonstrated the complexity of host-pathogen interactions and clarified the pathogenesis and immunological dynamics of T. annulata in nontraditional hosts. AcknowledgmentsThe authors extend gratitude to the heads of the veterinary hospitals and medical personnel for their assistance during sample collection. The authors extend their gratitude to the personnel of the parasitology departments of the Faculty of Veterinary Medicine, University of Baghdad, Iraq, for their collaboration and assistance during sample processing. Conflicts of interestThe authors declare no conflicts of interest. FindingThis research did not receive external funding. Authors’ contributionAll authors contributed equally. Data availabilityThe manuscript contains all data supporting this study’s findings, and no additional data sources are required. ReferencesAbd-Elmaleck, B.S., Abed, G.H. and Mandour, A.M. 2015. Histopathological and hematological changes in rat tissue after injected with Babesia and Theileria parasites. Int. J. Curr. Microbiol. App. Sci. 4(7), 260–275. Al-Rhman, L.Y., Al-Rubaii, H.M. and Zaid, N.W. 2009. Study the effect of ewe’s pregnancy stages on blood parasitemia of some protozoa infections (Theileria hirci and Anaplasma marginale) and total, differential of white blood cells counts. Iraqi J. Vet. 33(1), 10–18; doi:10.30539/iraqijvm.v33i1.708. Abd Elsayed, S.A., Rushdi, M., Abdel-Fattah, A.M. and Abdel-Salam, M. 2024. Impact of anemia on coagulation indices in theileriosis-Infected cattle. Assiut Vet. Med. J. 70(181), 83–99; doi:10.21608/avmj.2024.258361.1214. Abdel-Hamied, E., Aboelhadid, S., Arafa, W. and Mahmoud, M. 2020. Clinical, lipid peroxidation, antioxidant status and hemato-biochemical alterations in tropical theileriosis affected crossbred cows. J. Anim. Health Prod. 8(3), 150–157; doi:10.17582/journal.jahp/2020/8.3.150.157. Abosalif, K.O., Abdalla, A.E., Junaid, K., Eltayeb, L.B. and Ejaz, H. 2023. The interleukin-10 family: major regulators of the immune response against Plasmodium falciparum infections. Saudi J. Biol. Sci. 30(11), 103805; doi:10.1016/j.sjbs.2023.103805. Al-Hosary, A., Elsayed, H. and Ahmed, L. 2015. Oxidative stress and hematological profile in Theileria annulata clinically infected cattle before and after treatment. Assiut. Vet. Med. J. 61(144), 123–129; doi:10.21608/avmj.2015.170028. ALani, A.N. and Yousif, A.A. 2023. Detection of Theileria equi in Baghdad racing horses using hematological and molecular assay. Iraqi J. Vet. 47(1), 52–59; doi:10.30539/ijvm.v47i1.1501. Alsaadi, H.H. and Faraj, A.A. 2020. Traditional study and seroprevalence of Theileria spp. in camels in Middle of Iraq (Wasit, Al-Qadisiyah and Al-Najaf AlAshraf). Plant Arch. 20(2), 4158–4141. Clift, S.J., Collins, N.E., Oosthuizen, M.C., Steyl, J.C., Lawrence, J.A. and Mitchell, E.P. 2020. The pathology of pathogenic theileriosis in African wild artiodactyls. Vet. Pathol. 57(1), 24–48; doi:10.1177/0300985819879443. Clift, S.J., Steyl, J.C., Mitchell, E.P., Lawrence, J.A. and Hooijberg, E.H. 2021. Clinical and hematologic features of experimental theileriosis in roan calves (Hippotragus equinus). Ticks Tick Borne Dis. 12(2), 101644; doi:10.1016/j.ttbdis.2020.101644. Esmaeilnejad, B., Tavassoli, M., Samiei, A., Abbasi, A., Shafipour, A. and Esmaeilnejad, N. 2018. Histopathological changes and oxidative damage in hepatic tissue of rats experimentally infected with Babesia bigemina. Pol. J. Vet. Sci. 21(3), 517–524; doi:10.24425/124285. Hashimoto, M., Yokota, K., Kajimoto, K., Matsumoto, M., Tatsumi, A., Yamamoto, K., Hyodo, T., Matsushita, K., Minakawa, N. and Mita, T. 2020. Quantitative detection of Plasmodium falciparum using, LUNA-FL, A fluorescent cell counter. Microorganisms 8(9), 1356; doi:10.3390/microorganisms8091356. Hassan, A.H., Salmo, N.A. and Jabbar, S.A. 2012. Pathological and molecular diagnostic study of theileriosis in cattle in Sulaimaniyah province, Iraqi J. Vet. 36(2), 306–314; doi:10.30539/iraqijvm.v36i0E.435. Kawan, M.H. 2019. Molecular surveillance and phylogenetic analysis of Theileria annulata in bovine at Baghdad city/Iraq. Iraqi J. Vet. 43(1), 93–101; doi:10.30539/iraqijvm.v43i1.479. Ma, Q., Liu, J., Li, Z., Xiang, Q., Wang, J., Liu, A., Li, Y., Yin, H., Guan, G. and Luo, J. 2020. Clinical and pathological studies on cattle experimentally infected with Theileria annulata in China. Pathogens 9(9), 727; doi:10.3390/pathogens9090727. Onzere, C.K., Bastos, R.G., Bishop, R.P., Suarez, C.E. and Fry, L.M. 2024. Expression of IL-10 and TGF-β1 in horses experimentally infected with T. equi merozoites is associated with antibody production but not modulation of pro-inflammatory responses. Front. Immunol. 15, 1370255; doi:10.3389/fimmu.2024.1370255. Özdek, U., Oğuz, B., Kömüroğlu, A.U. and Değer, Y. 2020. Determination of the levels of serum oxidative indicator, cytokine and some biochemical parameters in horses naturally infected with Theileria equi. Ankara Univ. Vet. Fak. Derg. 67(3), 257–263; doi:10.33988/auvfd.603305. Ramzan, M.S., Rashid, M.I., Akbar, H., Avais, M. and Suleman, M. 2022. Theileria annulata: its propagation in rabbits for the attenuation of piroplasms in cross-bred calves. Animals 12(7), 813; doi:10.3390/ani12070813. Razmi, G., Yaghfoori, S., Mohri, M., Haghparast, A. and Tajeri, S. 2019. The haematological, proinflammatory cytokines and IgG changes during an ovine experimental theileriosis. Onderstepoort J. Vet. Res. 86(1), 1–6; doi:10.4102/ojvr.v86i1.1629. Ryskeldina, A., Korobeinikov, A., Tursunbay, N., Berdikulov, M., Shevtsov, A., Bauer, C., Mukhanbetkaliyev, Y. and Kuibagarov, M. 2024. A novel recombinant Theileria annulata surface protein as an antigen in indirect enzyme-linked immunosorbent assay for the serological diagnosis of tropical theileriosis. Vet. World. 17(8), 1936; doi:10.14202/vetworld.2024.1936-1942. Sabbar, K.H. and Aaiz, N.N. 2016. Molecular detection of Babesia bovis in cattle in Al-Qadisiyah province. Iraqi J. Vet. 40(2), 155–158; doi:10.30539/iraqijvm.v40i2.128. Sandhu, G., Grewal, A., Singh, A., Kondal, J., Singh, J. and Brar, R. 1998. Haematological and biochemical studies on experimental Theileria annulata infection in crossbred calves. Vet. Res. Commun. 22, 347–354; doi:10.1023/a:1006129306093. Saravanan, B., Bansal, G., Manigandan, L., Sankar, M., Ravindran, R. and Rao, J. 2011. Development of a non-radioactive probe generated by RAPD-PCR for the detection of Theileria annulata. Indian J. Anim. Sci. 81(11), 1089. Shaw, M.K. 2003. Cell invasion by Theileria sporozoites. Trends Parasitol. 19(1), 2–6; doi:10.1016/s1471-4922(02)00015-6. SPSS. 2019. Statistical Packages of Social Sciences In (Version 25.0). Sudan, V. and Paliwal, S. 2024. The interplay of cytokines in bovine tropical theileriosis: a mini review. Trop. Anim. Health Prod. 56(5), 174; doi:10.1007/s11250-024-04021-y. Tuli, A., Singla, L.D., Sharma, A., Bal, M.S., Filia, G. and Kaur, P. 2015. Molecular epidemiology, risk factors and hematochemical alterations induced by Theileria annulata in bovines of Punjab (India). Acta. Parasitol. 60(3), 378–390; doi:10.1515/ap-2015-0053. Tümer, K. and Kızıl, M. 2023. Circulatory cytokines during the piroplasm stage of natural Theileria annulata infection in cattle. Parasite Immunol. 45(5), 12973; doi:10.1111/pim.12973. Ullah, K., Numan, M., Alouffi, A., Almutairi, M.M., Zahid, H., Khan, M., Islam, Z.U., Kamil, A., Safi, S.Z., Ahmed, H., Tanaka, T. and Ali, A. 2022. Molecular characterization and assessment of risk factors associated with Theileria annulata infection. Microorganisms 10(8), 1614; doi:10.3390/microorganisms10081614. | ||
| How to Cite this Article |
| Pubmed Style Talab MA, Falih IB. Experimental induction of Theileria annulata infection in rabbits: Immunopathological, biochemical, and histopathological analysis. Open Vet. J.. 2025; 15(8): 3719-3726. doi:10.5455/OVJ.2025.v15.i8.36 Web Style Talab MA, Falih IB. Experimental induction of Theileria annulata infection in rabbits: Immunopathological, biochemical, and histopathological analysis. https://www.openveterinaryjournal.com/?mno=247469 [Access: January 25, 2026]. doi:10.5455/OVJ.2025.v15.i8.36 AMA (American Medical Association) Style Talab MA, Falih IB. Experimental induction of Theileria annulata infection in rabbits: Immunopathological, biochemical, and histopathological analysis. Open Vet. J.. 2025; 15(8): 3719-3726. doi:10.5455/OVJ.2025.v15.i8.36 Vancouver/ICMJE Style Talab MA, Falih IB. Experimental induction of Theileria annulata infection in rabbits: Immunopathological, biochemical, and histopathological analysis. Open Vet. J.. (2025), [cited January 25, 2026]; 15(8): 3719-3726. doi:10.5455/OVJ.2025.v15.i8.36 Harvard Style Talab, M. A. & Falih, . I. B. (2025) Experimental induction of Theileria annulata infection in rabbits: Immunopathological, biochemical, and histopathological analysis. Open Vet. J., 15 (8), 3719-3726. doi:10.5455/OVJ.2025.v15.i8.36 Turabian Style Talab, Mohanad Abbas, and Inam Badr Falih. 2025. Experimental induction of Theileria annulata infection in rabbits: Immunopathological, biochemical, and histopathological analysis. Open Veterinary Journal, 15 (8), 3719-3726. doi:10.5455/OVJ.2025.v15.i8.36 Chicago Style Talab, Mohanad Abbas, and Inam Badr Falih. "Experimental induction of Theileria annulata infection in rabbits: Immunopathological, biochemical, and histopathological analysis." Open Veterinary Journal 15 (2025), 3719-3726. doi:10.5455/OVJ.2025.v15.i8.36 MLA (The Modern Language Association) Style Talab, Mohanad Abbas, and Inam Badr Falih. "Experimental induction of Theileria annulata infection in rabbits: Immunopathological, biochemical, and histopathological analysis." Open Veterinary Journal 15.8 (2025), 3719-3726. Print. doi:10.5455/OVJ.2025.v15.i8.36 APA (American Psychological Association) Style Talab, M. A. & Falih, . I. B. (2025) Experimental induction of Theileria annulata infection in rabbits: Immunopathological, biochemical, and histopathological analysis. Open Veterinary Journal, 15 (8), 3719-3726. doi:10.5455/OVJ.2025.v15.i8.36 |